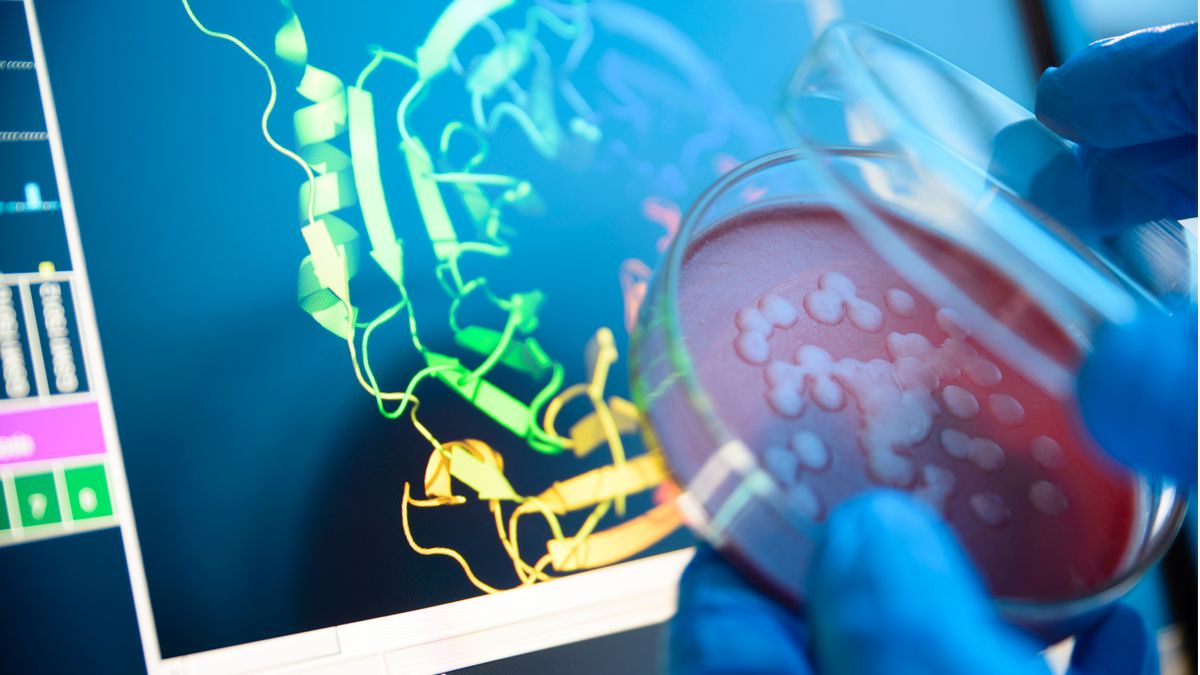
A researcher holding up a petri dish of bacteria to a computer image of the structure of a protein.

ABC Transporters: The Achilles Heel of Bacteria?
AI-driven structural prediction tools are helping researchers to design new strategies against antimicrobial resistance.
Complete the form below to unlock access to ALL audio articles.
Antimicrobial resistance (AMR) is a global health threat that occurs when bacteria, viruses, fungi and parasites no longer respond to antimicrobial medicines. AMR is a natural phenomenon whereby microbes develop genetic mutations to mitigate the lethal effects of antimicrobials; however, this process is accelerated by human activities such as the misuse and overuse of antimicrobials in humans, animals and plants.
Many strategies have been devised to try and combat AMR bacteria, such as the use of bacteriophages in phage therapy. However, there are still significant challenges to overcome before these therapies can be translated into human medicine.
Successful antimicrobial therapies must have little to no impact on an individual's microbiome. A promising strategy for combating AMR bacteria could lie in targeting bacteria-specific ATP-binding cassette (ABC) transporters. Given the specificity of ABC transporters, it could be possible to design inhibitors targeting AMR bacteria, while leaving the rest of the human microbiome unharmed.
Technology Networks caught up with Professor Heather Pinkett, professor in the Department of Molecular Biosciences at Northwestern University, to learn more about her research into the structure, function and regulation of ABC transporters ahead of her keynote presentation at the European Laboratory Research and Innovation Group (ELRIG) Drug Discovery 2025 event.
Why are ABC transporters such an important target for drug discovery?
One of the first things that comes to mind when we think about ABC transporters is multidrug resistance. P-glycoprotein, which is probably the most well-known ABC transporter, can recognize drugs it has never encountered before, bind to them and pump them out of the cell. This is problematic in chemotherapy, where you need the drug to be inside the tumor cell to be effective.
Another good example of an ABC transporter is the cystic fibrosis transmembrane conductance regulator. This is an interesting example because it's both a transporter and a channel. Specific drugs have been effective in overcoming mutations in the CFTR gene to treat cystic fibrosis.
Less studied are ABC transporters in bacterial pathogens, which are the focus of my research. With ABC transporters, there are exporters – transporters that remove materials from the cell – and importers. Bacteria tend to have a lot of importers because they utilize them to bring in all the nutrients that they need from their microenvironment. Both exporters and importers consist of a membrane embedded gate formed by the transmembrane domain that allows passage of materials into or out of the cell and an ATP powered cytoplasmic engine formed by the nucleotide binding domains. Importers utilize an additional protein to recognize these materials or “substrates” and bring them to the transporter. While most ABC transporters in bacteria are importers, in human cells, they are predominantly exporters, and that's extremely beneficial when considering targets for drugs.
These binding proteins are also very specific. Structural biology lets us pinpoint how a protein binds to its native substrate, revealing essential interactions and conformational changes that enhance specificity. Integrating structural data with computational approaches enables the design of inhibitors that bind tighter than and outcompete the native substrate. When you consider the human gut microbiome, this specificity allows you to selectively target “bad” bacteria.
Continuing to train structural prediction tools like AlphaFold offers a major benefit: the more structures that we solve and new experimental data is fed into the system, the more accurate machine learning based predictions will become.
As we solve the structures of these binding proteins, we can begin to utilize systems such as AlphaFold to predict the structures of unsolved proteins. We're approaching the point where we can analyze a predicted structure and estimate its accuracy based on what we already know about the structures that have been solved.
This highlights the synergy between traditional structural biology techniques such as X-ray crystallography, nuclear magnetic resonance spectroscopy and cryo electron microscopy (cryo EM), and the predictions from machine learning (ML). ML models are trained on datasets from known protein structures solved by these traditional techniques. However, challenges remain on the transporter side. Membrane proteins are inherently difficult to study experimentally. And so, in comparison to some of our soluble targets, we have less experimental data and fewer solved structures of membrane proteins in the database. When we use AI to make membrane protein structure predictions with limited training data, it is challenging to accurately predict novel domains and flexible regions important for protein function.
Credit: iStock.
I just returned from The Protein Society’s Annual Symposium, where several sessions centered on exciting developments in protein evolution and design. The field has advanced rapidly, from designing single peptides to engineering full proteins with altered or even novel activity. One example is cell surface receptors. Rather than modifying a known receptor’s sequence to bind to a new target, researchers now aim to design receptors de novo for specific recognition and integrate them into pathways for coordinated cellular function. This concept can be expanded to transporter design with the goal of engineering bacteria to produce valuable compounds and actively export them out of the cell, without the need for lysis. Designing ABC transporters that recognize and pump out novel substrates remains a major challenge in biotechnology, driven by our limited understanding of substrate recognition. Protein design has the potential to move us in the direction of cellular design with artificial cells.